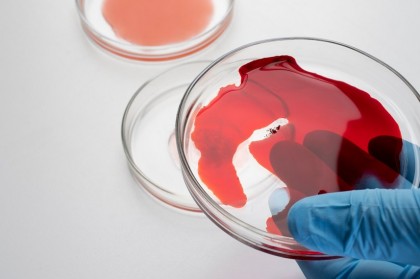
O proteină considerată „nemedicabilă” devine țintă terapeutică: inhibarea IGF2BP3 în leucemiile agresive

O proteină considerată „nemedicabilă” devine țintă terapeutică: inhibarea IGF2BP3 în leucemiile agresive
Autor: Airinei Camelia
Un studiu realizat la UCLA Health Jonsson Comprehensive Cancer Center și publicat în revista Haematologica descrie identificarea unei molecule mici capabile să inhibe o proteină-cheie implicată în dezvoltarea leucemiilor agresive. Cercetarea demonstrează pentru prima dată că proteina IGF2BP3, considerată mult timp imposibil de țintit farmacologic, poate fi blocată selectiv, deschizând perspective pentru o nouă clasă de terapii oncologice.
IGF2BP3 aparține unei familii de proteine de legare a ARN-ului mesager, active în mod normal doar în stadiile foarte timpurii ale dezvoltării embrionare. După naștere, expresia lor este în mare parte suprimată. În anumite tipuri de cancer, însă, inclusiv leucemii acute, tumori cerebrale, sarcoame și cancer mamar, IGF2BP3 este reactivată și contribuie la progresia tumorală.
Rolul acestei proteine este de a se lega de ARN-uri mesagere care codifică gene oncogene și de a le stabiliza, favorizând proliferarea celulară, supraviețuirea tumorală și menținerea celulelor inițiatoare de cancer. Deși importanța biologică a IGF2BP3 a fost recunoscută de peste un deceniu, lipsa unor structuri enzimatice clasice sau a unor „buzunare” de legare a făcut ca dezvoltarea unui inhibitor să fie extrem de dificilă.
Despre studiu
Cercetătorii au pornit de la ipoteza că, în loc să țintească o activitate enzimatică inexistentă, ar putea fi perturbată funcția esențială a proteinei: legarea de ARN-ul mesager. Pentru aceasta, a fost dezvoltat un test biochimic capabil să detecteze compuși care blochează interacțiunea dintre IGF2BP3 și ARN-urile sale țintă.
Folosind o platformă de screening de mare capacitate, au fost testate aproximativ 200.000 de molecule chimice. Compușii inițial identificați au fost ulterior analizați din punct de vedere structural, iar din această etapă a fost selectat un candidat principal, denumit I3IN-002. Molecula a putut fi sintetizată în laborator și a prezentat activitate biologică la concentrații micromolare, comparabile cu efectele observate atunci când gena IGF2BP3 este complet eliminată din celule.
Rezultate
Efecte selective asupra celulelor leucemice
Testele efectuate pe linii celulare de leucemie au arătat că I3IN-002 încetinește semnificativ proliferarea celulelor care depind de IGF2BP3 pentru creștere. În schimb, celulele care nu exprimau această proteină au fost mult mai puțin afectate, sugerând o specificitate ridicată a moleculei pentru ținta sa biologică.
În celulele IGF2BP3-pozitive, tratamentul cu I3IN-002 a indus apoptoză, a perturbat ciclul celular și a redus expresia mai multor gene oncogene a căror stabilitate depinde de această proteină. Aceste efecte au fost marcant diminuate atunci când IGF2BP3 fusese deja eliminată genetic, confirmând mecanismul de acțiune țintit.
Demonstrarea legării directe de IGF2BP3
Pentru a confirma că molecula acționează direct asupra IGF2BP3, autorii au utilizat o serie de teste complementare, inclusiv analize de legare ARN-proteină, teste de stabilitate termică și experimente de tip „afinitate pentru medicamente”. Toate aceste abordări au indicat că I3IN-002 se leagă fizic de IGF2BP3 și îi modifică structura funcțională, împiedicând interacțiunea cu ARN-urile oncogene.
Date preliminare in vivo
În modele murine de leucemie, administrarea I3IN-002 a demonstrat activitate biologică și efecte antileucemice măsurabile. Deși impactul in vivo a fost modest, autorii subliniază că acest rezultat este de așteptat pentru o moleculă de primă generație, principalul obiectiv fiind demonstrarea fezabilității țintirii IGF2BP3.
Semnificație biologică și terapeutică
Studiul oferă una dintre cele mai clare dovezi de până acum că proteinele de legare a ARN-ului, considerate mult timp „nemedicabile”, pot fi țintite cu molecule mici. IGF2BP3 reprezintă un exemplu de proteină oncofetală cu expresie predominant tumorală și rol esențial în menținerea malignității, ceea ce o face o țintă atractivă din punct de vedere terapeutic.
Prin inhibarea stabilizării ARN-urilor oncogene, I3IN-002 afectează nu doar proliferarea celulelor leucemice, ci și populația de celule inițiatoare ale leucemiei, considerate responsabile de recăderi și rezistență la tratament.
Limitări și direcții viitoare
Autorii recunosc că I3IN-002 este o moleculă de tip „dovada conceptului”, cu potență și stabilitate care necesită optimizare. Echipa lucrează în prezent la dezvoltarea unor analogi de generație următoare, cu proprietăți farmacologice îmbunătățite, mai potrivite pentru testare preclinică avansată și, eventual, studii clinice.
În paralel, descoperirea deschide o direcție mai largă de cercetare, sugerând că și alte proteine de legare a ARN-ului implicate în cancer ar putea deveni ținte terapeutice prin abordări similare.
Concluzii
Identificarea inhibitorului I3IN-002 demonstrează că IGF2BP3, o proteină centrală în leucemiile agresive și alte cancere dificile, poate fi inhibată farmacologic prin perturbarea interacțiunii sale cu ARN-ul mesager. Această descoperire reprezintă un pas conceptual major, nu doar pentru tratamentul leucemiilor, ci și pentru extinderea arsenalului terapeutic către o clasă de ținte moleculare până acum considerate inaccesibile.
Image by freepik on Freepik
Copyright ROmedic: Articolul se află sub protecția drepturilor de autor. Reproducerea, chiar și parțială, este interzisă!
- Dezechilibrele lipidice dezvăluie noi perspective asupra inflamației cronice în cancerul colorectal
- Riscul de mortalitate al imunoterapiei sau chimioterapiei convenționale depinde de IMC
- Nanoroboți pentru distrugerea celulelor canceroase
- Nou test de sânge pentru detectarea precoce a cancerului colorectal
- Despre leucemie
- E posibil sa am leucemie?
- Pete rosii pe piele si raceli frecvente..este oare leucemie?
- Leucemie sau alt cancer ?
- Se confrunta cineva cu leucemia?
- Leucemia cronica
- Mostenire leucemie
- URGENT Transfuzii de Sange